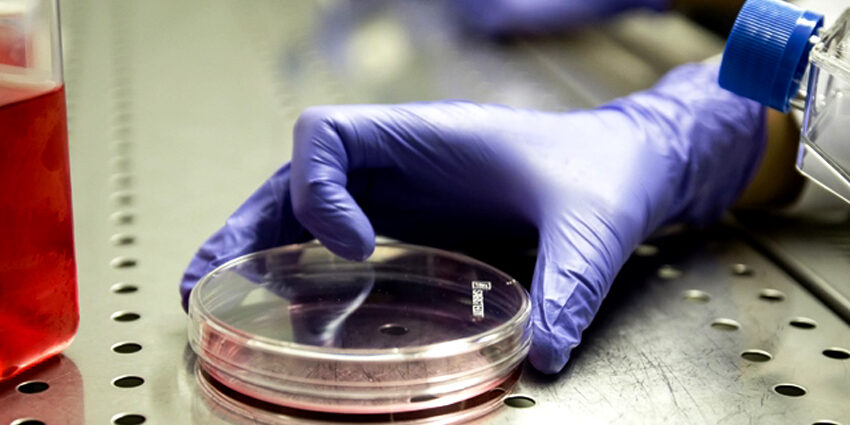
Pillole2

Si è molto dibattuto in passato sulla possibilità di estendere il concetto di brevettabilità anche al settore farmaceutico. Le principali resistenze erano di ordine morale, derivanti dall’importanza che il farmaco riveste per la salute umana e quindi dall’opportunità di ostacolare la diffusione delle metodologie di produzione (Floridia, 1985).
D’altro canto, negli ultimi decenni la ricerca farmaceutica è stata condotta in prevalenza dall’industria; è quindi necessario concedere la possibilità di tutelare con il brevetto gli investimenti effettuati, al fine di evitare che l’invenzione possa essere sfruttata indiscriminatamente dalle concorrenti dell’impresa innovatrice, a tutto discapito dell’attività di ricerca (Valentini, 1996).
Le industrie farmaceutiche fanno ricorso principalmente a due tipologie di brevetto: di prodotto e di procedimento. Il primo determina la protezione di un determinato principio attivo, mentre il secondo tutela solamente uno specifico processo di sintesi di una certa molecola (Garattini e Capeccia, 1984). Nella maggior parte dei casi esistono possibilità alternative per sintetizzare uno stesso principio attivo, il brevetto di prodotto è prevalente rispetto a quello di procedimento.
Fra i brevetti di prodotto è possibile introdurre un’ulteriore distinzione fra quelli di sbarramento e di selezione. Il brevetto di sbarramento copre una famiglia di composti caratterizzati dallo stesso gruppo funzionale di base e, presumibilmente, da effetti terapeutici similari. Il brevetto di selezione protegge, invece, una “piccola famiglia” di composti (o addirittura una singola molecola) che rientra nella formula generale di una “grande famiglia”, ma è caratterizzata da effetti terapeutici originali.
Questi due tipi di tutela riflettono innovazioni diverse. Il brevetto di sbarramento è utile nel caso di importanti innovazioni riguardanti la scoperta di una nuova famiglia di molecole: la sola presenza di un brevetto di selezione permetterebbe ad altre imprese, infatti, di produrre molecole analoghe, eliminando il vantaggio competitivo dell’impresa innovatrice.
Il brevetto di selezione, d’altra parte, è necessario per le innovazioni di sviluppo riguardanti una modifica della formula chimica già nota, finalizzata al miglioramento in termini di farmacocinetica (assorbimento, metabolismo ed escrezione) e tollerabilità (riduzione della tossicità e degli effetti collaterali), oppure con differente impiego terapeutico della stessa.